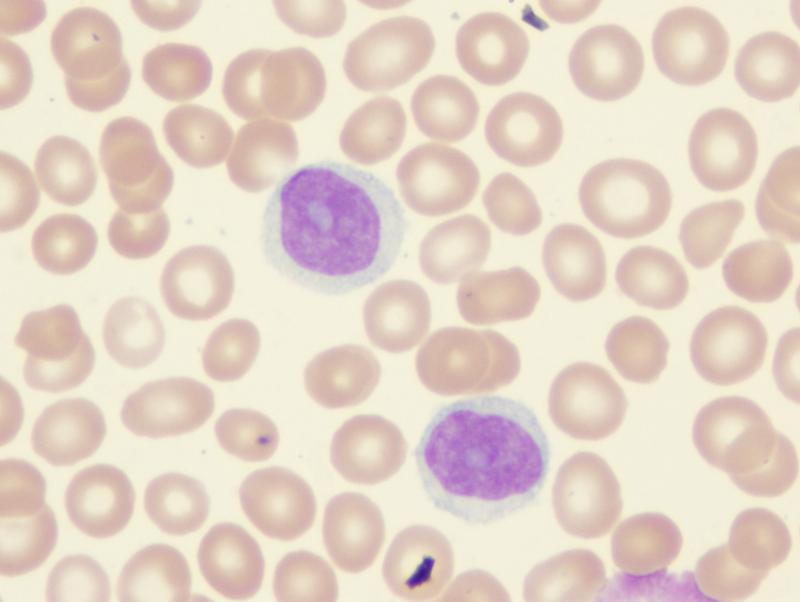

For patients with Hodgkin’s lymphoma who have completed a first-line chemotherapy regimen that includes doxorubicin, bleomycin, vinblastine, and dacarbazine (ABVD), neutrophil and lymphocyte counts may predict disease prognosis, as reported in a study from Singapore.
Specifically, progression-free survival (PFS) after ABVD treatment was poorer in the presence of a high neutrophil count (>0.96 vs ≤0.96 109/L: hazard ratio [HR], 2.99; p=0.0392), a low lymphocyte count (≤1.54 vs >1.54 109/L; HR, 3.95; p=0.0038), and a high neutrophil-to-lymphocyte ratio (>0.68 vs ≤0.68; p=0.0078). [Hematol Rep 2023;15:108-118]
In multivariable Cox proportional hazards analysis, low post-treatment lymphocyte count (HR, 6.80, 95 percent confidence interval [CI], 1.56–29.59; p=0.0107), but not high post-treatment neutrophil count (HR, 6.978, 95 percent CI, 0.927–52.356; p=0.0592), remained an independent predictor of poorer PFS.
“Chemotherapy-induced neutropenia (CIN) is conventionally regarded as a potentially dangerous side effect of cytotoxic chemotherapy, so it is interesting that multiple studies have recently demonstrated survival benefits in patients with CIN. In our study, we showed that … grade 3 neutropenia may potentially confer PFS benefit following ABVD-based chemotherapy,” according to the investigators.
While the exact mechanisms underlying the survival advantage seen in patients with CIN remain unclear, the investigators believe that the presence of CIN may imply lower cytotoxicity.
Meanwhile, “lymphopenia at diagnosis is an established poor prognostic factor for advanced Hodgkin’s lymphoma, but the prognostic implications of chemotherapy-induced lymphopenia are less clear. It has been postulated that lymphopenia reflects an underlying immunosuppressed state or may result from tumour-induced lymphocyte destruction and alterations in immune homeostasis in cancer,” the investigators pointed out. [N Engl J Med 1998;339:1506-1514; Cancer Res 2009;69:5383-5391]
“Interestingly, recovery from lymphopenia did not improve prognosis, and it [is said] that lymphopenia recovery might not fully reflect post-treatment changes in lymphocyte subtype and lymphocyte diversity, both of which are critical to normal immune and antitumor activity. Similar trends toward poorer survival with treatment-induced lymphopenia have been noted in cervical cancer and other solid tumours,” they added. [Int J Clin Oncol 2020;25:955-962; Int J Radiat Oncol Biol Phys 2021;111:936-948]
The analysis included 131 patients (median age 29 years, 52.7 percent men, 76.3 percent had nodular sclerosing) who were treated for classical Hodgkin’s lymphoma at the National Cancer Centre Singapore using ABVD-based regimens. Disease stage (based on German Hodgkin Study Group criteria) was early favourable in 40 patients (30.5 percent), early unfavourable in 47 (35.9 percent), and advanced in 44 (33.6 percent).
Overall survival (OS) and PFS were excellent, with a 5-year OS of 99.2 percent and a 5-year PFS of 88.2 percent, as the investigators noted. At the time of analysis, 11.5 percent of patients had relapsed or progressed, and 3.1 percent of patients had died. After treatment, the median neutrophil count was 1.64 109/L, the median lymphocyte count was 1.42 109/L, and the median neutrophil-to-lymphocyte ratio was 1.14.
“The findings of our study may imply opportunities for the development of novel strategies in patient management and follow-up,” according to the investigators.
For example, novel therapies such as interleukin (IL)-7 immunotherapy have been explored in animal models to enhance lymphocyte recovery after treatment-induced lymphopenia. Another potential strategy is the reinfusion of autologous lymphocytes combined with granulocyte-macrophage colony stimulating factor (GM-CSF) to stimulate lymphocyte recovery after chemotherapy. [Int J Radiat Oncol Biol Phys 2021;109:1559-1569; J Immunol 2005;175:162-170; J Clin Oncol Off J Am Soc Clin Oncol 2002;20:58-64]
“As mentioned, post-treatment neutrophil count levels may guide the dose adjustment of chemotherapy and potentially serve as an adjunct measure to the interim PET/CT scan when considering patients for escalation or de-escalation of treatment regimens,” the investigators pointed out.
“In addition, since low post-treatment neutrophil count has a potential PFS advantage, this also perhaps suggests against the prophylactic use of GM-CSF without a compelling reason to do so,” they said.